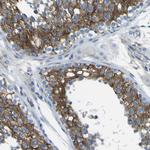
STIM1 Antibody in Immunohistochemistry (Paraffin) (IHC (P))

Search
Invitrogen
STIM1 Polyclonal Antibody
{{$productOrderCtrl.translations['antibody.pdp.commerceCard.promotion.promotions']}}
{{$productOrderCtrl.translations['antibody.pdp.commerceCard.promotion.viewpromo']}}
{{$productOrderCtrl.translations['antibody.pdp.commerceCard.promotion.promocode']}}: {{promo.promoCode}} {{promo.promoTitle}} {{promo.promoDescription}}. {{$productOrderCtrl.translations['antibody.pdp.commerceCard.promotion.learnmore']}}
产品信息
PA5-82455
种属反应
宿主/亚型
分类
类型
抗原
偶联物
形式
浓度
规格
纯化类型
保存液
内含物
保存条件
运输条件
RRID
产品详细信息
Immunogen sequence: VHPGSLVEKL PDSPALAKKA LLALNHGLDK AHSLMELSPS APPGGSPHLD SSRSHSPSSP DPDTPSPVGD SRALQASRNT RIPHLAGKKA VAEEDNGSIG EETDSSPGRK KFPLKIFK
Highest antigen sequence indentity to the following orthologs: Rat - 93%, Mouse - 91%.
靶标信息
STIM1 (stromal interacting molecule; also known as GOK) acts as a sensor of calcium depletion within the endoplasmic reticulum and transduces the signal to Orai1, the presumptive CRAC channel at the plasma membrane. Following decrease of luminal calcium concentration, STIM1 oligomerizes and induces Orai1 to enable entry of extracellular calcium into the cytoplasm. However, the precise mechanism of STIM1-Orai1 interaction has not been elucidated yet. Many questions also remain to be solved around STIM1 functional distribution. It turns out that STIM1 associates with growing ends of microtubules and is involved in endoplasmic reticulum tubule extension.
仅用于科研。不用于诊断过程。未经明确授权不得转售。
篇参考文献 (0)
生物信息学
蛋白别名: stim1 {ECO:0000312|RGD:1306831}; STIM1L; Stromal interaction molecule 1
基因别名: D11S4896E; GOK; IMD10; Sim; STIM1; STRMK; TAM; TAM1
UniProt ID: (Human) Q13586, (Rat) P84903
Entrez Gene ID: (Human) 6786, (Rat) 361618